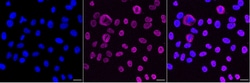
Invitrogen KHSRP Recombinant Rabbit Monoclonal Antibody (23GB6435), Invitrogen

missing translation for 'onlineSavingsMsg'
Learn More
Learn More
Invitrogen™ KHSRP Recombinant Rabbit Monoclonal Antibody (23GB6435), Invitrogen™


Rabbit Recombinant Monoclonal Antibody
Brand: Invitrogen™ MA553960
This item is not returnable.
View return policy
Description
The KHSRP gene encodes a multifunctional RNA-binding protein implicated in a variety of cellular processes, including transcription, alternative pre-mRNA splicing, and mRNA localization.
Specifications
| KHSRP | |
| Recombinant Monoclonal | |
| Unconjugated | |
| KHSRP | |
| 6330409F21Rik; Far upstream element-binding protein 2; FBP2; Fubp2; FUSE binding protein 2; FUSE-binding protein 2; KH type-splicing regulatory protein; KHE3; KHSRP; KH-type splicing regulatory protein; KH-type splicing regulatory protein (FUSE binding protein 2); KSRP; MAP2 RNA trans-acting protein 1; MAP2 RNA trans-acting protein MARTA1; MARTA1; p75 | |
| Rabbit | |
| Affinity chromatography | |
| RUO | |
| 16549, 171137, 8570 | |
| -20°C | |
| Liquid |
| Flow Cytometry, Western Blot, Immunocytochemistry | |
| 23GB6435 | |
| PBS with 50% glycerol and 0.02% sodium azide; pH 7.4 | |
| Q3U0V1, Q92945, Q99PF5 | |
| KHSRP | |
| A synthesized peptide derived from human KHSRP (50-100AA). | |
| 100 μL | |
| Primary | |
| Human, Mouse, Rat | |
| Antibody | |
| IgG |
Product Content Correction
Your input is important to us. Please complete this form to provide feedback related to the content on this product.
Product Title
Spot an opportunity for improvement?Share a Content Correction